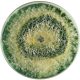
Microorganismos benéficos como promotores de economía circular en los campos agrícolas

Microorganismos benéficos como promotores de economía circular en los campos agrícolas
El microbiólogo de BioLIMSA PERÚ, Mirko Lino, se refiere a la importancia de seguir invirtiendo en investigación y desarrollo de cepas nativas de microorganismos benéficos para los cultivos.
En la actualidad los microorganismos benéficos tales como bacterias y hongos principalmente se han convertido en una herramienta primordial. No solo en el biocontrol de plagas y enfermedades para diversos cultivos del Perú y del mundo, sino que también representan una carta de presentación ante el mundo, avalando una tecnología eficiente, sustentable y eco-amigable.
Sin embargo, a pesar de estas ventajas tenemos mucho por investigar y desarrollar, sobre todo nuestra matriz biotecnológica nacional ya que muchos de los productos más utilizados en el Perú son importados debido a que la industria de biopesticidas nacional es aún incipiente y por ende por ahora hay poca inversión en I+D+i. En empresas como agroindustrial LIMSA, entre otras, venimos apostando por la aplicación de la biotecnología agrícola a partir de estos microorganismos.
 Mirko Lino, microbiólogo BioLIMSA PERÚ.
Mirko Lino, microbiólogo BioLIMSA PERÚ.
Ahora bien, importar biopesticidas a base de cepas no nativas puede afectar la efectividad de los productos en campo, debido a que los microorganismos vivos para prevenir/controlar una plaga o enfermedad primero deben resistir las condiciones ambientales antes de ejercer su efecto biocontrolador. Utilizar cepas no adaptadas a los condiciones temporales-climáticas de los cultivos de interés, el efecto biocontrolador se verá disminuido considerablemente.
Por ello, el desarrollo de nuevos productos debe apuntar al uso de cepas nativas, así como al de metabolitos multi-sitio que sean producidos tanto en los mismos campos de cultivo o desarrolladas en Plantas-laboratorios externos para ser devueltos a los cultivos. De esta manera promoveremos el biocontrol bajo un enfoque de economía circular a partir de microorganismos benéficos nativos.








